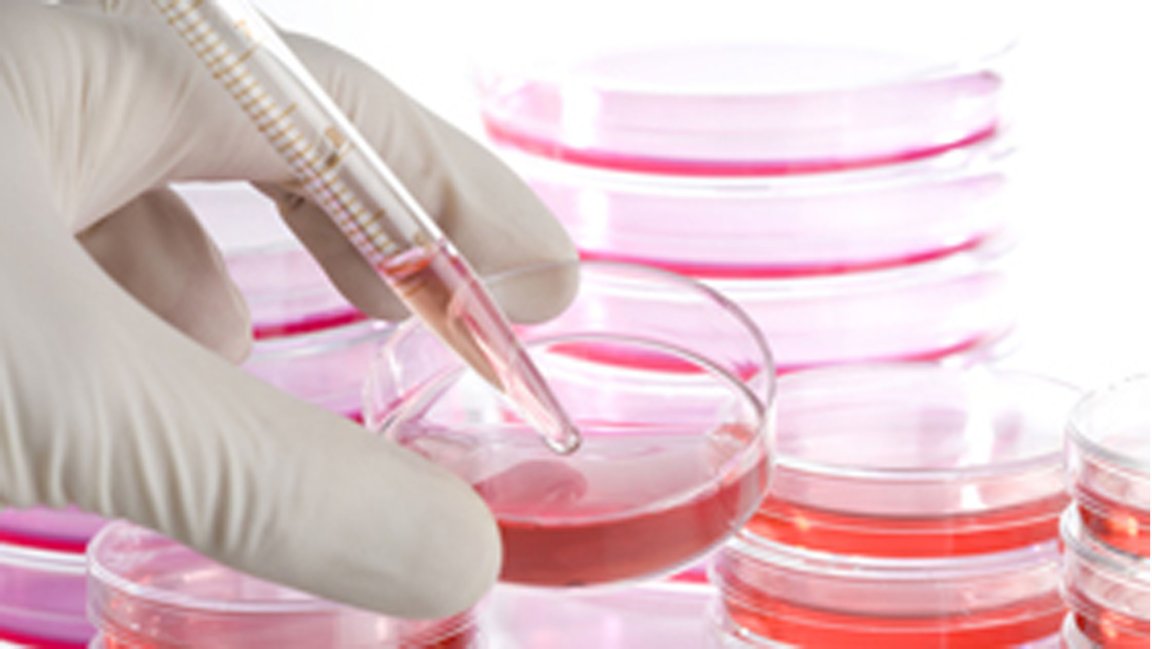

The War Against Arthritis
Arthritis is an extremely common condition that affects over 350 million people worldwide. It causes joint cartilage to break down, which can produce an unbearable amount of pain. Because cartilage has no blood supply or nerves, it can’t regrow on its own. Sometimes, the only curable option for someone to take is invasive surgery that involves bone drilling or implanting pre-made implants into the affected area.
But now, a team of Australian surgeons and researchers from the ARC Center of Excellence for Electromaterials Science (ACES) and St. Vincent’s Hospital, Melbourne have invented a new method of treating arthritis, and it addresses the issue of cartilage having no blood supply or nerves.
Their findings were published in the journal Biofabrication.
3D Printing With Stem Cell ‘Ink’

The team created a mobile 3D printing pen, dubbed the ‘BioPen,’ which is a revolutionary device that allows users to 3D print cartilage directly into the patient’s body. The BioPen works similarly to a 3Doodler, instead using a mixture of the patient’s own stem cells and a protective hydrogel bioink.
When the stem cells are ‘printed’ into the affected area, the hydrogel bioink acts to protect them while they regrow. It hardens into a 3D scaffold, later dissolving back into the body after time. Lab tests conducted revealed that more than 97% of stem cells were still alive and thriving after just one week.
Medicinal Breakthrough
With the BioPen, we would be able to print on-the-spot rather than estimate the dimensions of the pre-made implant. We would also see a decrease in the hundreds of thousands of arthritis-induced knee and hip replacement surgeries every year.
This example, of scientists and clinicians working together, demonstrates an extremely innovative outcome. “The BioPen project highlight both the challenges and exciting opportunities in multidisciplinary research. When we get it right, we can make extraordinary progress at a rapid rate,” noted Professor Gordon Wallace, ACES Director.
Since the BioPen encourages the body to mend itself, we could see some advancements in various 3D Bioprinting procedures in the near future. It could even be modified to print a range of substances such as tissue, including skin and muscle tissue.
With the ability to 3D Bioprint this extensively, how far can we go with medicine?